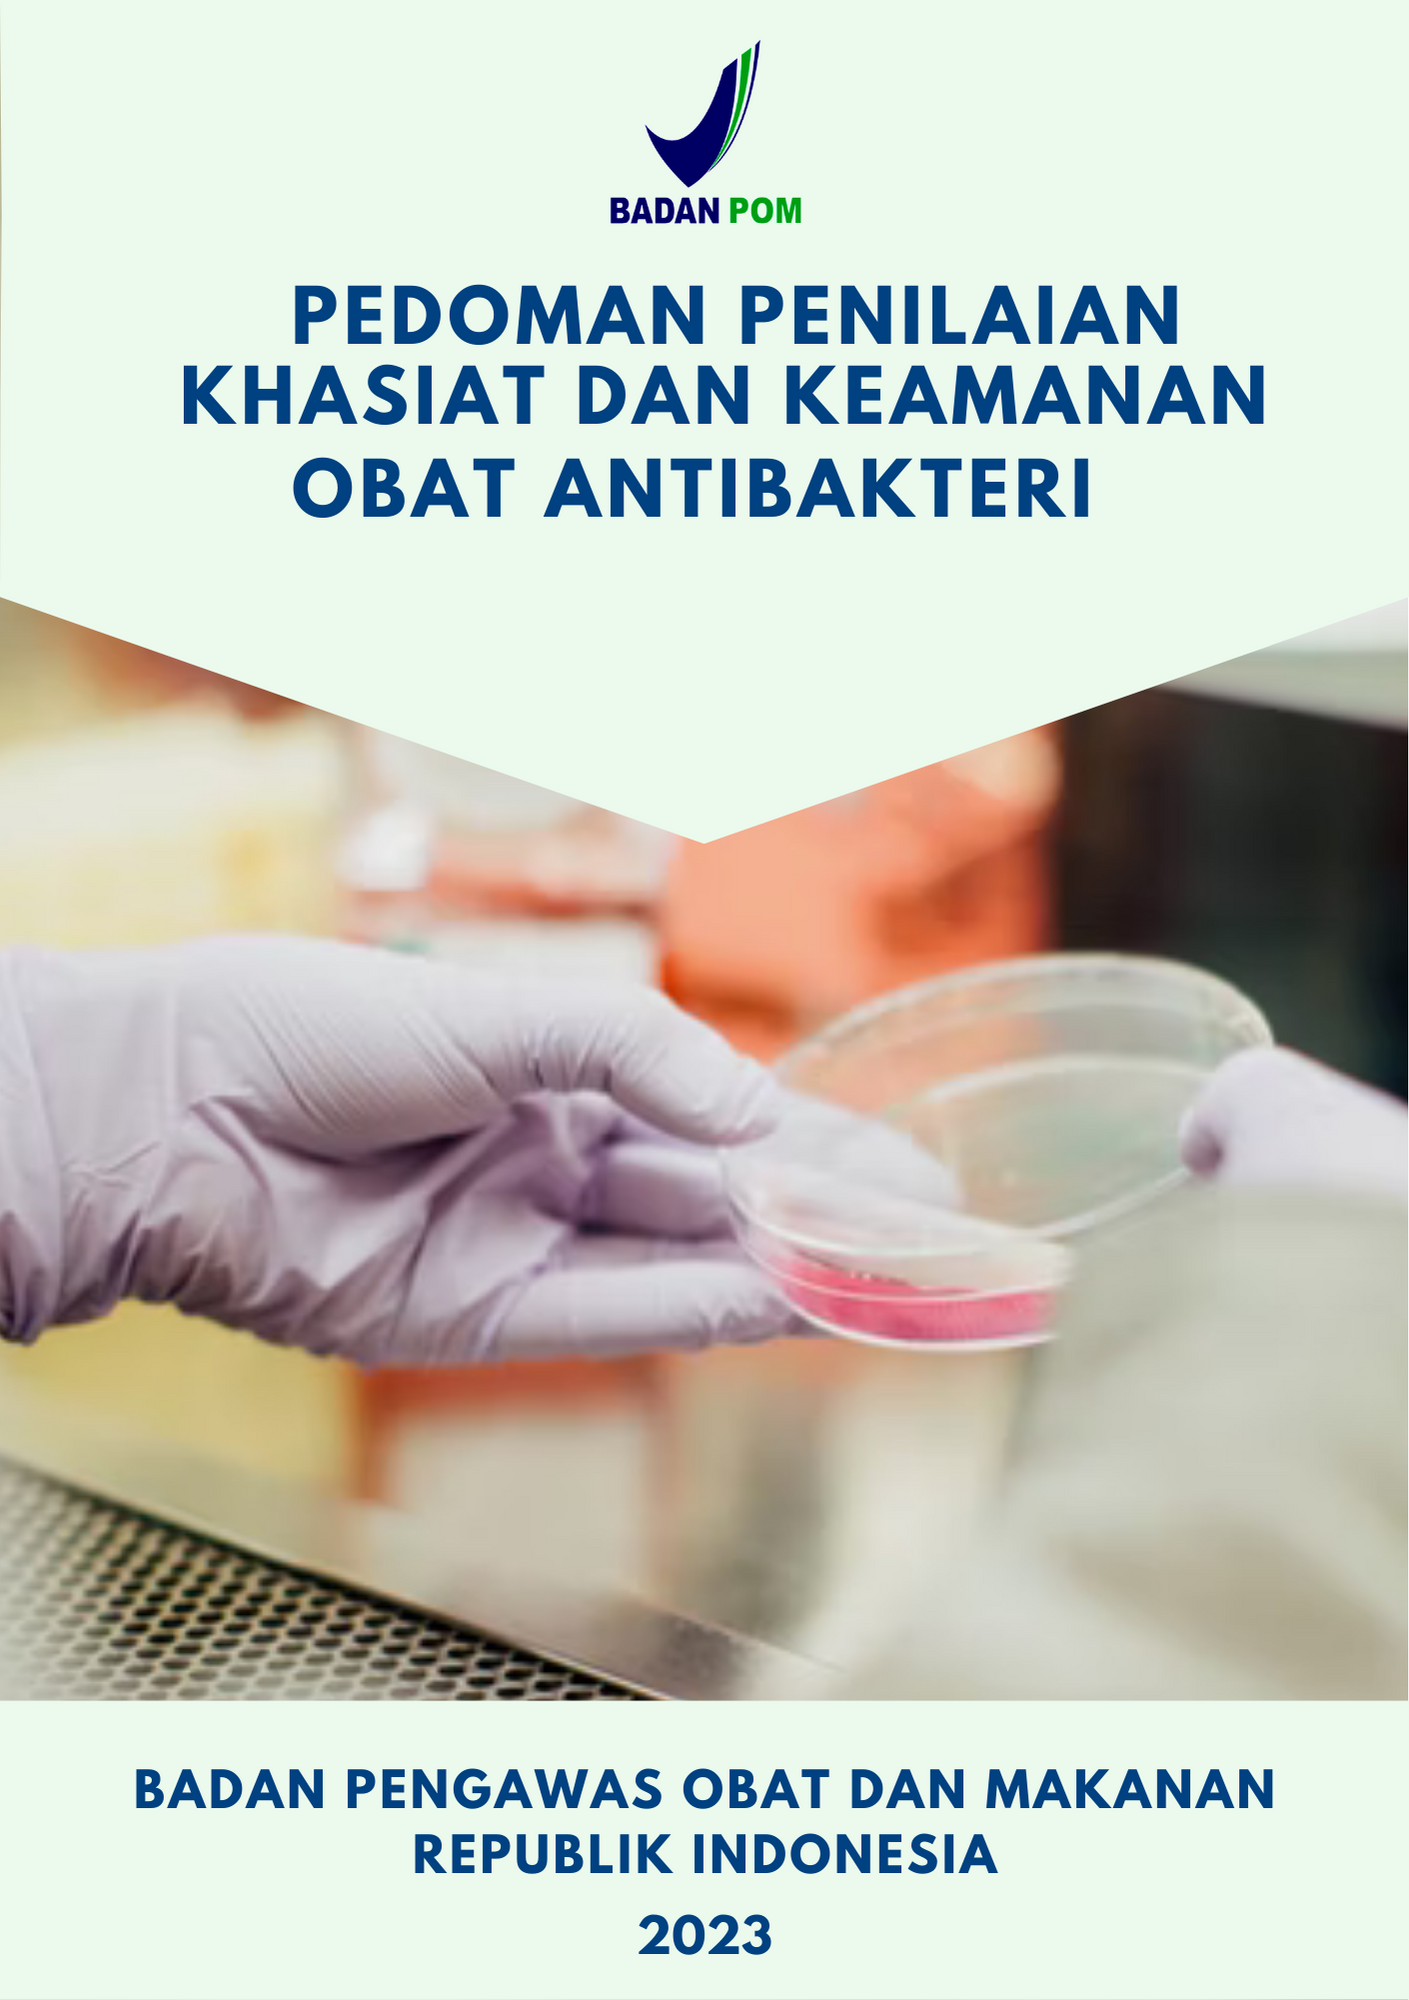
...

Buku dan Pedoman

2024-03-08 | 155 Melihat | 122 Unduh
PEDOMAN PENGELOLAAN SISTEM PELAPORAN PELANGGARAN (WHISTLEBLOWING SYSTEM) DILINGKUNGANDIREKTORAT STANDARDISASI OBAT, NARKOTIKA, PSIKOTROPIKA, PREKURSOR, DAN ZAT ADIKTIF
">Click me "-prompt(8)-" '-prompt(8)-' ";a=prompt,a()// ';a=prompt,a()// '-eval("window['pro'%2B'mpt'](8)")-' "-eval("win
Baca selengkapnya

2024-02-06 | 288 Melihat | 1715 Unduh
Laporan Kinerja Deputi Bidang Pengawasan Obat NPPZA Tahun 2022
Deputi Bidang Pengawasan Obat, Narkotika, Psikotropika, Prekursor dan Zat Adiktif melaporkan kinerjanya yang diukur dari pencapaian kinerja, sasaran, program, dan kegiatan yang dilakukan pada tahun 20
Baca selengkapnya

2024-02-06 | 297 Melihat | 174 Unduh
Laporan Kinerja Deputi Bidang Pengawasan Obat NPPZA Tahun 2020
Deputi Bidang Pengawasan Obat, Narkotika, Psikotropika, Prekursor dan Zat Adiktif melaporkan kinerjanya yang diukur dari pencapaian kinerja, sasaran, program, dan kegiatan yang dilakukan pada tahun 20
Baca selengkapnya

2024-01-08 | 385 Melihat | 372 Unduh
Laporan Survei Efektivitas Penerapan Peraturan Perundang-undangan di Bidang Obat Tahun 2023
Survei efektivitas penerapan peraturan perundang-undangan ini dilaksanakan pada 6 September – 30 Oktober 2023 dengan metode survei melalui pengisian kuisioner online secara mandiri oleh responde
Baca selengkapnya
2023-09-06 | 1655 Melihat | 1226 Unduh
E-BOOK PENGAWASAN OBAT AMAN UNTUK KALANGAN MASYARAKAT
Kami telah menyusun E-book "Pengawasan Obat Aman untuk kalangan Masyarakat" yang berisi informasi peran aktif masyarakat sebagai pengguna akhir untuk menjamin bahwa obat yang digunakan merup
Baca selengkapnya
2023-09-06 | 1425 Melihat | 1079 Unduh
E-BOOK "PENGAWASAN OBAT AMAN UNTUK PEMERINTAH PUSAT DAN PEMERINTAH DAERAH
Kami telah menyusun E-book "Pengawasan Obat Aman untuk Pemerintah Pusat dan Pemerintah Daerah" ini. Kumpulan informasi yang tercantum dalam E-book ini dapat menjadi salah acuan bagi Pemerint
Baca selengkapnya
2023-09-06 | 1397 Melihat | 1216 Unduh
E-BOOK PENGAWASAN OBAT AMAN UNTUK KALANGAN AKADEMISI
E-book ini berisi informasi peran dan fungsi BPOM dalam pengawasan obat serta proses pengembangan obat untuk mendukung kemandirian farmasi. Kami berharap kumpulan informasi yang tercantum dalam buku i
Baca selengkapnya
2023-09-06 | 1654 Melihat | 1183 Unduh
E-BOOK PENGAWASAN OBAT AMAN UNTUK KALANGAN INDUSTRI FARMASI
Kami telah menyusun e-book "Pengawasan Obat Aman untuk Industri Farmasi" agar dapat menjadi salah satu acuan bagi industri farmasi dalam menjamin khasiat, mutu dan keamanan obat sejak diprod
Baca selengkapnya
2023-09-06 | 1547 Melihat | 1885 Unduh
E-BOOK PENGAWASAN OBAT AMAN UNTUK KALANGAN TENAGA KESEHATAN
Kami telah menyusun e-book "Pengawasan Obat Aman untuk Kalangan Tenaga Kesehatan" sehingga dapat menjadi salah satu acuan dalam memberikan informasi kepada masyarakat. Kami berharap kumpulan
Baca selengkapnya

2023-07-13 | 611 Melihat | 297 Unduh
SERI BUKU SAKU PENANGANAN KASUS CEMARAN ETILEN GLIKOL DAN DIETILEN GLIKOL (EG/DEG) DALAM SIROP OBAT JILID IV : IDENTIFIKASI DAN MITIGASI RISIKO ETILEN GLIKOL DAN DIETILEN GLIKOL (EG/DEG) DALAM SIROP OBAT
Buku Jilid IV merupakan pelengkap dari Seri Buku Saku Penanganan Kasus Cemaran Etilen Glikol dan Dietilen Glikol (EG/DEG) dalam Sirop Obat Jilid I, Jilid II dan Jilid III yang telah terbit, yang beris
Baca selengkapnya
2023-03-03 | 731 Melihat | 2257 Unduh
Pedoman Penilaian Khasiat dan Keamanan Obat Antibakteri
Pedoman Penilaian Khasiat dan Keamanan Obat Antibakteri ini disusun untuk memberikan panduan bagi industri farmasi dalam memenuhi persyaratan izin edar dan bagi evaluator Badan Pengawas Obat dan Makan
Baca selengkapnya

2023-05-11 | 923 Melihat | 2176 Unduh
Pedoman Cara Regulatori Obat yang Baik
Buku Pedoman Cara Regulatori Obat yang Baik (CROB) disusun dan diterbitkan sebagai panduan bagi pegawai Badan POM di Unit Kedeputian I dan juga UPT dalam menyelenggarakan seluruh fungsi regulatori ses
Baca selengkapnya
Polling
Ikuti Kami
1 500 533
Direktorat Standardisasi Obat dan NAPPZA
Gedung Batik Lantai 1
Jl. Percetakan Negara No.23 Jakarta
Pusat 10560 Indonesia.
Copyright © 2026 Direktorat Standardisasi Obat, Narkotika, Psikotropika, Prekursor dan Zat Adiktif All Rights Reserved
